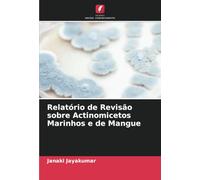
Relatório de Revisão sobre Actinomicetos Marinhos e de Mangue

Al momento non ci sono offerte disponibili per la tua ricerca.
Risultati di ricerca
Relatório de base sobre a economia verde no Gana
Prodotti simili

42,67 €
Amazon.it
Spedizione gratuita
Relatório de Revisão sobre Actinomicetos Marinhos e de Mangue
35,90 €
Amazon.it
Spedizione gratuita